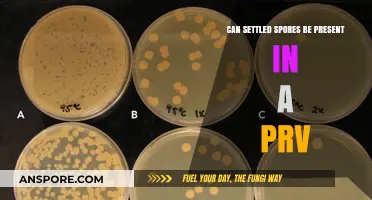
Settled Spores in PRVs: Understanding Their Presence and Impact

Rubbing alcohol, typically composed of isopropyl alcohol, is widely recognized for its antiseptic properties and effectiveness against a variety of bacteria, viruses, and fungi. However, its ability to kill bacterial spores, which are highly resistant dormant forms of bacteria, remains a subject of debate. While rubbing alcohol can disrupt the cell membranes of vegetative bacteria, bacterial spores possess a robust outer coating that makes them significantly more resilient to common disinfectants. Studies suggest that high concentrations of isopropyl alcohol and prolonged exposure may have some sporicidal activity, but it is generally less effective compared to specialized spore-killing agents like autoclaving or certain chemical sterilants. As a result, rubbing alcohol is not typically relied upon for complete spore eradication in critical applications such as medical sterilization.
| Characteristics | Values |
|---|---|
| Effectiveness on Bacterial Spores | Rubbing alcohol (isopropyl alcohol) is generally ineffective against bacterial spores. |
| Mechanism of Action | Alcohol disrupts cell membranes but does not penetrate spore coats effectively. |
| Concentration Required | Even at high concentrations (70-90%), it fails to kill bacterial spores. |
| Common Bacterial Spores Affected | Clostridium difficile, Bacillus anthracis, and other spore-forming bacteria are resistant. |
| Alternative Disinfectants | Spores require spore-specific agents like bleach (sodium hypochlorite), autoclaving, or hydrogen peroxide. |
| Applications | Rubbing alcohol is effective against vegetative bacteria, fungi, and viruses but not spores. |
| CDC/WHO Recommendations | Not recommended for spore decontamination; use spore-specific methods instead. |
| Stability of Spores | Spores can survive alcohol exposure and remain viable for disinfection. |
Explore related products
What You'll Learn
- Effectiveness of rubbing alcohol concentration on bacterial spore destruction
- Comparison of rubbing alcohol and other spore-killing agents
- Role of exposure time in spore eradication using rubbing alcohol
- Impact of bacterial spore type on rubbing alcohol efficacy
- Practical applications of rubbing alcohol in spore decontamination processes

Effectiveness of rubbing alcohol concentration on bacterial spore destruction
Rubbing alcohol, typically composed of isopropyl alcohol, is a common household disinfectant, but its effectiveness against bacterial spores is concentration-dependent. Bacterial spores, such as those from *Clostridium difficile* and *Bacillus* species, are notoriously resistant to many disinfectants due to their robust cell wall and dormant state. While 70% isopropyl alcohol is effective against vegetative bacteria, concentrations below 90% often fail to destroy spores. This is because lower concentrations allow spores to remain in a protective, dehydrated state, preventing the alcohol from fully penetrating and denaturing their proteins.
To achieve spore destruction, a minimum of 90% isopropyl alcohol is recommended, with 99% solutions being more reliable. The higher concentration ensures sufficient alcohol molecules are present to disrupt the spore’s protective layers and inactivate its core components. However, even at 99%, prolonged exposure (at least 10–15 minutes) is necessary to ensure complete spore eradication. This is why rubbing alcohol is often less practical for spore decontamination compared to specialized sporicides like bleach or hydrogen peroxide.
Practical application of this knowledge is crucial in healthcare and laboratory settings. For instance, when disinfecting surfaces potentially contaminated with spore-forming bacteria, using 99% isopropyl alcohol and allowing it to remain wet on the surface for the full contact time is essential. Lower concentrations, such as the commonly available 70% solution, should be avoided for spore decontamination, as they may provide a false sense of security. Always verify the alcohol concentration and follow manufacturer guidelines for proper use.
A comparative analysis highlights the limitations of rubbing alcohol against spores. While ethanol at 70% concentration is effective against most vegetative bacteria and enveloped viruses, isopropyl alcohol requires a higher concentration and longer contact time to impact spores. This disparity underscores the importance of selecting the appropriate disinfectant based on the target pathogen. For bacterial spores, relying solely on rubbing alcohol, even at high concentrations, may not be sufficient without additional measures or alternative agents.
In conclusion, the effectiveness of rubbing alcohol on bacterial spore destruction hinges on its concentration and application method. While 90–99% solutions can be effective with prolonged exposure, they are not as reliable or efficient as dedicated sporicides. For practical purposes, reserve high-concentration isopropyl alcohol for situations where spores are not the primary concern, and opt for proven sporicidal agents when dealing with spore contamination. Always prioritize evidence-based practices to ensure thorough disinfection.
Milorganite and Milky Spores: Can You Apply Them Together?
You may want to see also

Comparison of rubbing alcohol and other spore-killing agents
Rubbing alcohol, typically isopropyl alcohol at concentrations of 70% or higher, is a common disinfectant effective against many bacteria, viruses, and fungi. However, its efficacy against bacterial spores is limited. Spores, such as those of *Clostridioides difficile* and *Bacillus anthracis*, possess a resilient outer coat that resists desiccation, heat, and chemicals. While rubbing alcohol can disrupt the cell membranes of vegetative bacteria, it fails to penetrate the spore’s protective layers, leaving them largely unharmed. This limitation necessitates a comparison with other spore-killing agents to identify more effective alternatives.
One of the most potent spore-killing agents is autoclaving, which uses steam under pressure at 121°C (250°F) for 15–30 minutes. This method denatures spore proteins and disrupts their DNA, ensuring complete sterilization. However, autoclaving requires specialized equipment and is impractical for many household or field settings. Another effective agent is hydrogen peroxide, particularly in vaporized form or at concentrations of 6–7%. It penetrates spore coats and generates reactive oxygen species that damage cellular components. Unlike rubbing alcohol, hydrogen peroxide is sporicidal but requires careful handling due to its corrosive nature and potential health risks.
Chlorine bleach (sodium hypochlorite) is another widely used sporicidal agent, effective at concentrations of 5,000–10,000 ppm. It oxidizes spore proteins and lipids, rendering them inactive. However, bleach is corrosive to metals and fabrics, and its efficacy decreases in the presence of organic matter. In contrast, glutaraldehyde, a cold sterilant, is effective against spores at 2% concentration but requires prolonged exposure (10–45 minutes) and proper ventilation due to its toxic fumes. These agents, while more effective than rubbing alcohol, come with trade-offs in terms of practicality, safety, and accessibility.
For practical applications, the choice of spore-killing agent depends on the context. In healthcare settings, autoclaving remains the gold standard for sterilizing surgical instruments, while hydrogen peroxide vapor is used for room decontamination. In households, chlorine bleach is a cost-effective option for disinfecting surfaces, though it must be used cautiously. Rubbing alcohol, despite its limitations, remains valuable for general disinfection of non-critical items. Understanding these differences ensures the appropriate selection of agents to address specific spore-related challenges.
Can Apple TV Spread Spores? Unveiling the Truth Behind the Myth
You may want to see also

Role of exposure time in spore eradication using rubbing alcohol
Rubbing alcohol, typically isopropyl alcohol, is a common disinfectant, but its effectiveness against bacterial spores is limited. Unlike vegetative bacteria, spores are highly resistant due to their thick, protective protein coats and low metabolic activity. While isopropyl alcohol at concentrations of 60-90% can disrupt cell membranes and denature proteins in active bacteria, it struggles to penetrate the spore’s durable outer layers. This raises a critical question: can prolonged exposure to rubbing alcohol overcome this resistance and eradicate spores?
The role of exposure time in spore eradication is a delicate balance between efficacy and practicality. Studies indicate that bacterial spores, such as *Clostridioides difficile*, require significantly longer contact times with isopropyl alcohol compared to vegetative cells. For instance, a 70% isopropyl alcohol solution may need up to 60 minutes of continuous exposure to achieve spore inactivation, whereas vegetative bacteria are typically neutralized within seconds. This extended duration is impractical in most clinical or household settings, where disinfection must be swift and efficient. However, in controlled environments like laboratories, prolonged exposure can be a viable strategy for spore decontamination.
To maximize the effectiveness of rubbing alcohol against spores, consider the following steps: first, ensure the alcohol concentration is at least 70%, as lower concentrations are ineffective. Second, apply the alcohol liberally to the surface, maintaining a wet layer for the entire exposure period. Third, monitor the contact time meticulously, as even a slight reduction can compromise efficacy. For example, using a timer ensures consistency, especially in high-stakes scenarios like medical instrument sterilization. Caution: prolonged exposure to rubbing alcohol can damage certain materials, such as plastics or rubber, so test surfaces beforehand.
Comparatively, other methods like autoclaving or hydrogen peroxide vapor are far more effective at spore eradication, often requiring only minutes at elevated temperatures or concentrations. However, these methods are resource-intensive and not always accessible. Rubbing alcohol, despite its limitations, remains a useful alternative in situations where spores are not the primary concern, or when more potent methods are unavailable. Its role is supplementary rather than primary in spore decontamination protocols.
In conclusion, while rubbing alcohol can theoretically kill bacterial spores given sufficient exposure time, its practical application is constrained by the lengthy duration required. For most users, the trade-off between time and efficacy makes it an unreliable choice for spore eradication. However, in specific contexts where prolonged exposure is feasible, it can serve as a stopgap measure. Understanding these limitations ensures informed decision-making in disinfection practices, prioritizing both safety and efficiency.
Exploring Spores: Nature's Ingenious Dispersal Mechanism for Survival and Spread
You may want to see also
Explore related products

Impact of bacterial spore type on rubbing alcohol efficacy
Rubbing alcohol, typically composed of 70% isopropyl alcohol, is a common disinfectant, but its efficacy against bacterial spores varies significantly depending on the spore type. Clostridioides difficile spores, for instance, are notoriously resistant to alcohol-based sanitizers due to their thick protein coat and impermeable exosporium. In contrast, Bacillus subtilis spores, often used as surrogates in lab studies, show intermediate susceptibility, with complete inactivation requiring prolonged exposure (over 10 minutes) at higher concentrations (90%+ isopropyl alcohol). Understanding these differences is critical for selecting appropriate disinfectants in healthcare and laboratory settings.
To maximize rubbing alcohol’s effectiveness against bacterial spores, consider the following steps: 1) Use at least 70% isopropyl alcohol for general disinfection, but note this concentration is ineffective against most spores. 2) For spore-specific decontamination, opt for 100% isopropyl alcohol and extend contact time to 30–60 minutes. 3) Pre-clean surfaces to remove organic matter, as debris can shield spores from alcohol exposure. 4) Combine with mechanical action, such as scrubbing, to disrupt spore coatings and enhance penetration. These measures are particularly vital when dealing with Clostridium botulinum or Bacillus anthracis spores, which are highly resistant to alcohol.
A comparative analysis reveals that rubbing alcohol’s efficacy is not just spore-dependent but also influenced by environmental factors. For example, temperature plays a role: spores exposed to 70% isopropyl alcohol at 25°C show minimal reduction, whereas at 50°C, inactivation rates increase by up to 40%. Humidity also matters; dry conditions can cause alcohol to evaporate prematurely, reducing contact time. In healthcare, this translates to practical advice: use alcohol-based disinfectants in controlled environments and pair them with spore-specific agents like hydrogen peroxide or chlorine for comprehensive sterilization.
Persuasively, the limitations of rubbing alcohol against bacterial spores underscore the need for targeted disinfection strategies. While it excels against vegetative bacteria and enveloped viruses, its failure against spores like Geobacillus stearothermophilus—commonly found in soil and dust—highlights its inadequacy in critical settings. For instance, in surgical instrument sterilization, relying solely on alcohol can lead to spore survival, increasing infection risks. Instead, adopt a dual approach: use alcohol for immediate surface decontamination followed by autoclaving (121°C, 15–30 minutes) to ensure spore eradication.
Descriptively, the interaction between rubbing alcohol and bacterial spores is a battle of chemistry and biology. Alcohol disrupts cell membranes by denaturing proteins and dissolving lipids, but spores’ dormant state and protective layers render them impervious. The cortex layer, rich in peptidoglycan, resists alcohol penetration, while the exosporium acts as a physical barrier. Only under extreme conditions—high alcohol concentrations, prolonged exposure, and elevated temperatures—does alcohol begin to compromise spore integrity. This explains why, despite its widespread use, rubbing alcohol remains a poor choice for spore decontamination without adjunctive methods.
Can Mold Spores Trigger Pink Eye? Uncovering the Surprising Connection
You may want to see also

Practical applications of rubbing alcohol in spore decontamination processes
Rubbing alcohol, typically composed of isopropyl alcohol, is a common household disinfectant, but its efficacy against bacterial spores is limited. Unlike vegetative bacteria, spores are highly resistant to environmental stressors, including many chemical agents. However, rubbing alcohol can still play a practical role in spore decontamination processes when used strategically. For instance, it can be employed as a preliminary step to reduce the overall microbial load, making subsequent sterilization methods more effective. This is particularly useful in laboratory settings where equipment must be pre-cleaned before autoclaving or exposure to more potent sporicides like bleach or hydrogen peroxide.
In medical and industrial applications, rubbing alcohol is often used to disinfect surfaces that may harbor spore-forming bacteria such as *Clostridium difficile* or *Bacillus anthracis*. While it does not kill spores directly, its ability to rapidly inactivate vegetative cells prevents the formation of new spores. For example, in healthcare settings, 70% isopropyl alcohol is routinely used to wipe down medical devices and surfaces to minimize the risk of spore contamination. This practice is especially critical in environments like operating rooms or intensive care units, where spore-forming pathogens can pose significant risks.
A practical application of rubbing alcohol in spore decontamination involves its use in combination with other methods. For instance, in food processing plants, surfaces are often pre-treated with 70% isopropyl alcohol to remove organic matter and reduce bacterial counts before applying heat or chemical sterilants. This two-step approach ensures that spores are exposed to sterilizing agents in a cleaner environment, increasing the likelihood of successful decontamination. Similarly, in laboratory settings, glassware and metal instruments are often wiped with rubbing alcohol before autoclaving to enhance the sterilization process.
Despite its limitations, rubbing alcohol’s accessibility and ease of use make it a valuable tool in spore decontamination protocols. For home users, a 70% isopropyl alcohol solution can be used to disinfect high-touch surfaces like doorknobs, countertops, and electronic devices, reducing the risk of spore-forming bacteria spreading. However, it is crucial to note that rubbing alcohol should not be relied upon as the sole agent for spore decontamination. Instead, it should be part of a broader strategy that includes physical methods like heat or more potent chemical agents. Always follow manufacturer guidelines and safety precautions when using rubbing alcohol, especially in confined spaces or on sensitive materials.
In summary, while rubbing alcohol cannot kill bacterial spores directly, its practical applications in spore decontamination processes are undeniable. By reducing microbial loads, pre-treating surfaces, and complementing other sterilization methods, it serves as a versatile and effective tool in both professional and home settings. Understanding its role and limitations ensures its proper use in maintaining hygiene and preventing spore-related infections.
Best Time to Apply Milky Spore for Grub Control in Lawns
You may want to see also
Frequently asked questions
Rubbing alcohol (isopropyl alcohol) is effective against many bacteria, viruses, and fungi, but it is not reliable for killing bacterial spores. Spores are highly resistant and require more potent methods like autoclaving or specialized chemicals.
Bacterial spores have a thick, protective outer layer that makes them resistant to common disinfectants like rubbing alcohol. Spores can survive exposure to alcohol, requiring extreme heat or specific sporicidal agents to be destroyed.
To kill bacterial spores, use methods like autoclaving (high-pressure steam), hydrogen peroxide, or bleach-based solutions specifically labeled as sporicidal. These methods are more effective at penetrating and destroying spore structures.



![McKesson Isopropyl Rubbing Alcohol 70% [1 Count] USP First Aid Antiseptic, 16 oz](https://m.media-amazon.com/images/I/61-YReH3nKL._AC_UY218_.jpg)






![McKesson Isopropyl Rubbing Alcohol 70% [1 Count] USP First Aid Antiseptic, 32 oz](https://m.media-amazon.com/images/I/61lYiXl9g9L._AC_UY218_.jpg)